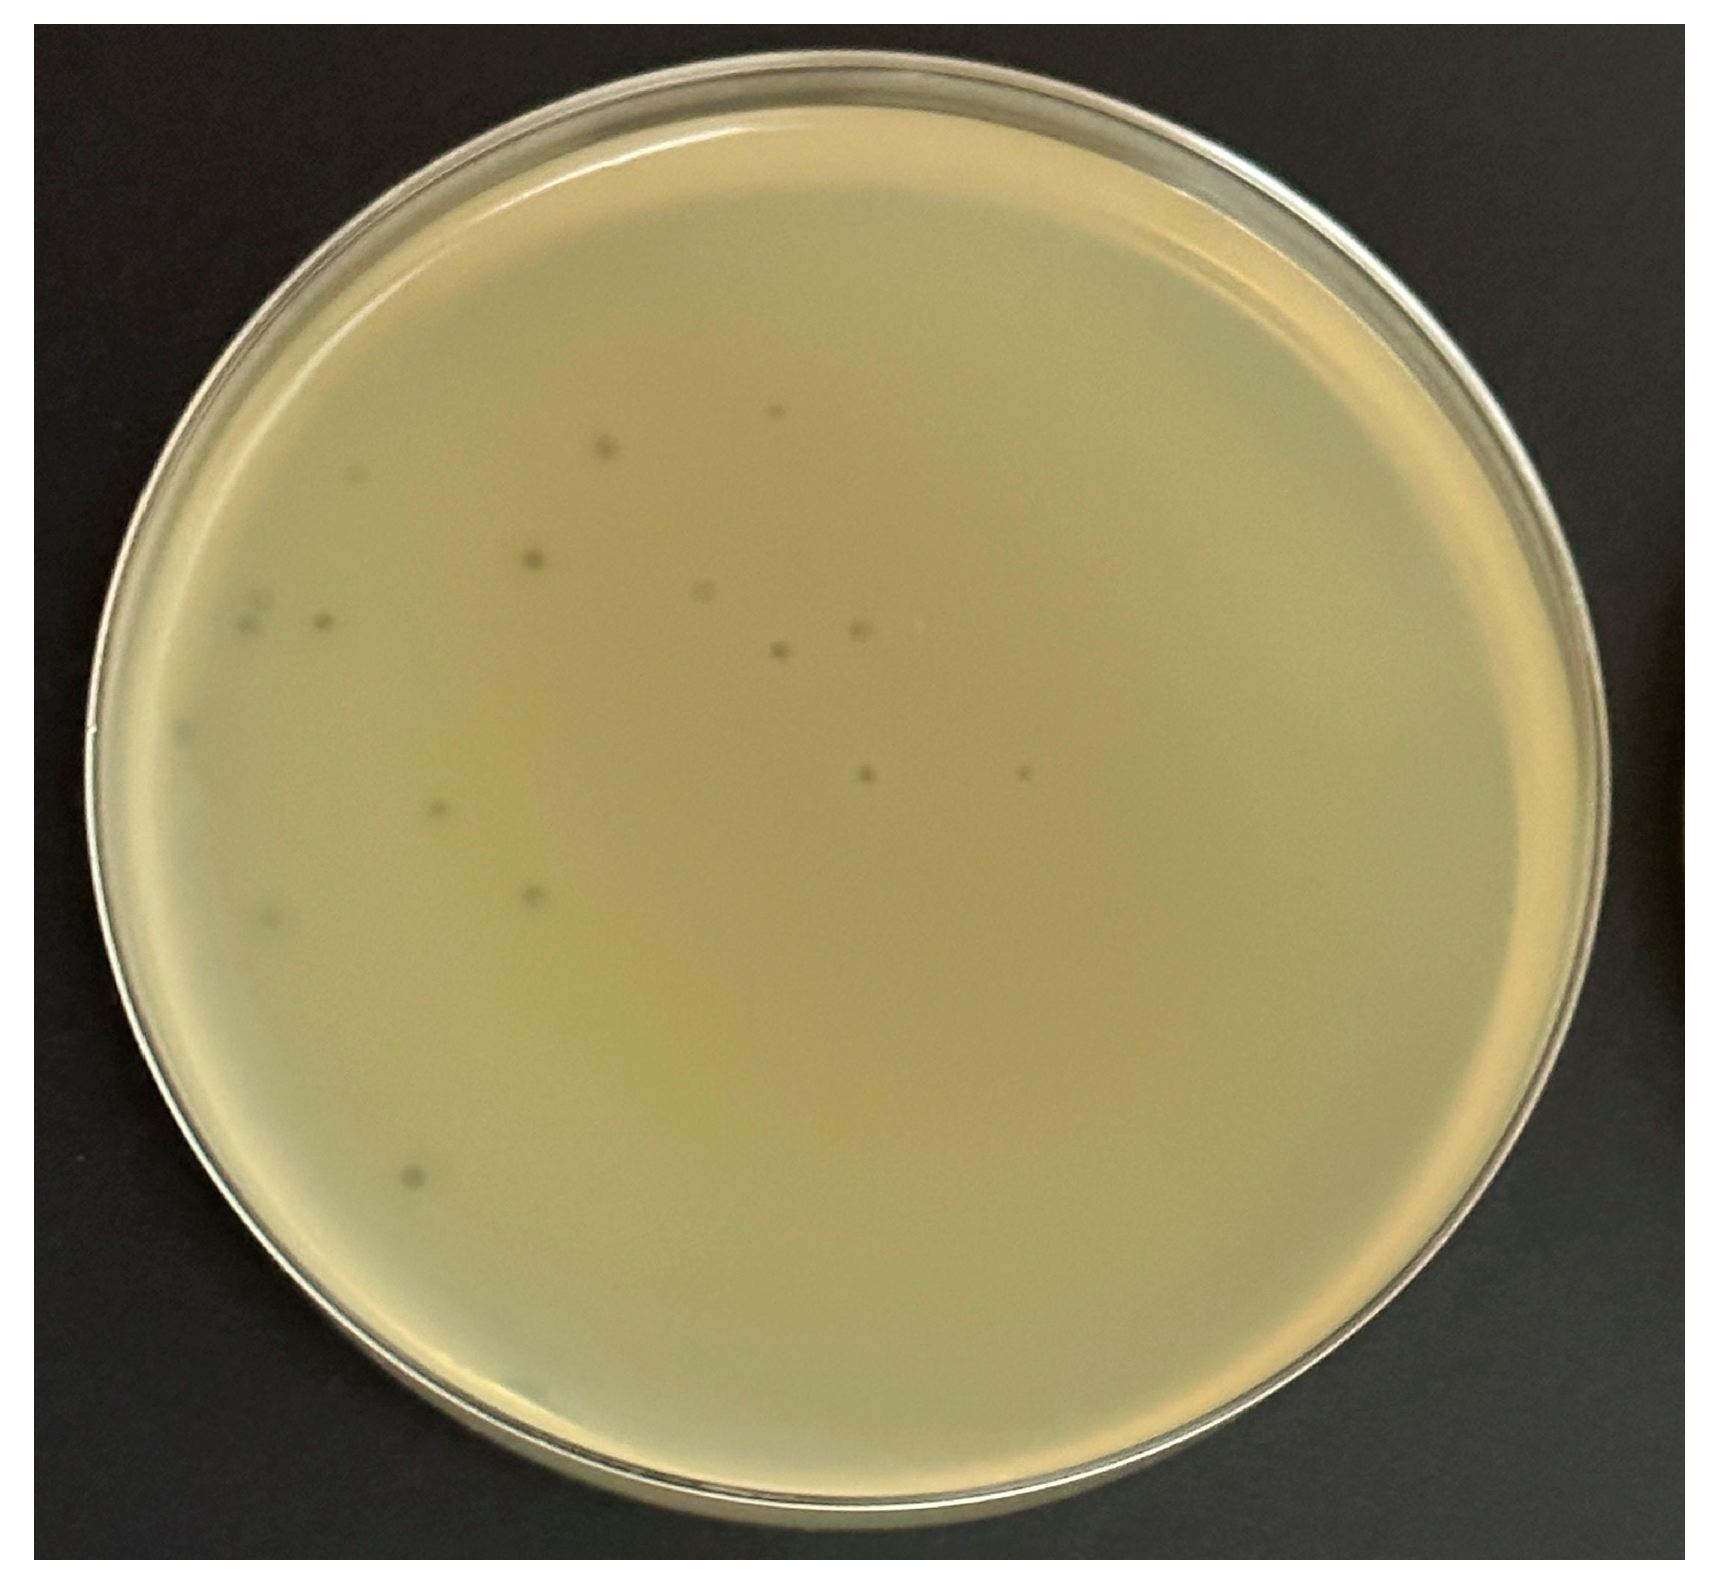

Isolation, Characterization, and Comparative Genomic Analysis of Bacteriophage Ec_MI-02 from Pigeon Feces Infecting Escherichia coli O157:H7
Abstract
1. Introduction
2. Results
2.1. Isolation and Host Range of the Phage Ec_MI-02 Active against E. coli O157:H7 Using a Spot Test and an Efficiency of Plating (EOP) Test
2.2. Plaque Size and Morphology of the Phage Ec_MI-02
2.3. Effect of pH and Temperature on the Phage Ec_MI-02
2.4. Effects of Chemical Disinfectants on the Phage Ec_MI-02
2.5. Adsorption Time, Adsorption Rate Constant, Latent Period, and Burst Size of the Phage Ec_MI-02
2.6. Transmission Electron Microscopy (TEM) of the Phage Ec_MI-02
2.7. Genomic Analysis and Bioinformatics of the Phage Ec_MI-02
3. Discussion
4. Materials and Methods
4.1. Propagation Media
4.2. Cultivation of Host Bacterium E. coli O157:H7
4.3. Isolation, Purification, and Propagation of the Phage Ec_MI-02
4.4. Determination of the Host Range of the Phage Ec_MI-02
4.5. Plaque Morphology of the Phage Ec_MI-02
4.6. Effect of Physical and Chemical Agents on Stability and Viability of the Phage Ec_MI-02
4.7. Adsorption Time, Adsorption Rate Constant, Latent Period, and Burst Size of the Phage Ec_MI-02
4.8. TEM of the Phage Ec_MI-02
4.9. Isolation of DNA of the Phage Ec_MI-02
4.10. Genome Sequencing and Assembly of the Phage Ec_MI-02
4.11. Bioinformatics Analysis of the Phage Ec_MI-02
4.12. Statistical Analysis
Supplementary Materials
Author Contributions
Funding
Data Availability Statement
Acknowledgments
Conflicts of Interest
References
- Escherich, T. The intestinal bacteria of the neonate and breast-fed infant. Rev. Infect. Dis. 1988, 10, 1220–1225. [Google Scholar] [CrossRef] [PubMed]
- Cordonnier, C.; Etienne-Mesmin, L.; Thévenot, J.; Rougeron, A.; Rénier, S.; Chassaing, B.; Darfeuille-Michaud, A.; Barnich, N.; Blanquet-Diot, S.; Livrelli, V. Enterohemorrhagic Escherichia coli pathogenesis: Role of long polar fimbriae in Peyer’s patches interactions. Sci. Rep. 2017, 7, 44655. [Google Scholar] [CrossRef]
- Ho, N.K.; Henry, A.C.; Johnson-Henry, K.; Sherman, P.M. Pathogenicity, host responses and implications for management of enterohemorrhagic Escherichia coli O157:H7 infection. Can. J. Gastroenterol. 2013, 27, 281–285. [Google Scholar] [CrossRef]
- Rahal, E.A.; Kazzi, N.; Nassar, F.J.; Matar, G.M. Escherichia coli O157:H7—Clinical aspects and novel treatment approaches. Front. Cell. Infect. Microbiol. 2012, 2, 138. [Google Scholar] [CrossRef]
- Leyer, G.J.; Wang, L.L.; Johnson, E.A. Acid adaptation of Escherichia coli O157:H7 increases survival in acidic foods. Appl. Environ. Microbiol. 1995, 61, 3752–3755. [Google Scholar] [CrossRef]
- Price, S.B.; Wright, J.C.; DeGraves, F.J.; Castanie-Cornet, M.-P.; Foster, J.W. Acid resistance systems required for survival of Escherichia coli O157:H7 in the bovine gastrointestinal tract and in apple cider are different. Appl. Environ. Microbiol. 2004, 70, 4792–4799. [Google Scholar] [CrossRef]
- Brookes, V.J.; Jordan, D.; Davis, S.; Ward, M.P.; Heller, J. Saltelli global sensitivity analysis and simulation modelling to identify intervention strategies to reduce the prevalence of Escherichia coli O157 contaminated beef carcasses. PLoS ONE 2015, 10, e0146016. [Google Scholar] [CrossRef]
- Slutsker, L.; Ries, A.A.; Greene, K.D.; Wells, J.G.; Hutwagner, L.; Griffin, P.M. Escherichia coli O157: H7 diarrhea in the United States: Clinical and epidemiologic features. Ann. Intern. Med. 1997, 126, 505–513. [Google Scholar] [CrossRef] [PubMed]
- Boyce, T.G.; Swerdlow, D.L.; Griffin, P.M. Escherichia coli O157:H7 and the hemolytic–uremic syndrome. N. Engl. J. Med. 1995, 333, 364–368. [Google Scholar] [CrossRef] [PubMed]
- Honish, L.; Predy, G.; Hislop, N.; Chui, L.; Kowalewska-Grochowska, K.; Trottier, L.; Kreplin, C.; Zazulak, I. An Outbreak of E. coli O157: H7 hemorrhagic colitis associated with unpasteurized gouda cheese. Can. J. Public Health 2005, 96, 182–184. [Google Scholar] [CrossRef] [PubMed]
- Kovacs, M.J.; Roddy, J.; Grégoire, S.; Cameron, W.; Eidus, L.; Drouin, J. Thrombotic thrombocytopenic purpura following hemorrhagic colitis due to Escherichia coli O157: H7. Am. J. Med. 1990, 88, 177–179. [Google Scholar] [CrossRef]
- Thomas, M.K.; Murray, R.; Flockhart, L.; Pintar, K.; Fazil, A.; Nesbitt, A.; Marshall, B.; Tataryn, J.; Pollari, F. Estimates of foodborne illness–related hospitalizations and deaths in Canada for 30 specified pathogens and unspecified agents. Foodborne Pathog. Dis. 2015, 12, 820–827. [Google Scholar] [CrossRef]
- CDC. E. coli Outbreak Linked to Ground Beef. 2022. Available online: https://www.cdc.gov/ecoli/2022/o157h7-09-22/index.html (accessed on 28 October 2022).
- CDC. E. coli Outbreak with Unknown Food Source. 2022. Available online: https://www.cdc.gov/ecoli/2022/o157h7-08-22/index.html (accessed on 28 October 2022).
- Doane, C.A.; Pangloli, P.; Richards, H.A.; Mount, J.R.; Golden, D.A.; Draughon, F.A. Occurrence of Escherichia coli O157:H7 in diverse farm environments. J. Food Prot. 2007, 70, 6–10. [Google Scholar] [CrossRef]
- Moghadam, A.K.; Schmidt, C.; Grier, K. The impact of E. coli O157:H7 recalls on live cattle futures prices: Revisited. Food Policy 2013, 42, 81–87. [Google Scholar] [CrossRef]
- Solomon, E.B.; Pang, H.; Matthews, K.R. Persistence of Escherichia coli O157:H7 on lettuce plants following spray irrigation with contaminated water. J. Food Prot. 2003, 66, 2198–2202. [Google Scholar] [CrossRef]
- Delaquis, P.; Bach, S.; Dinu, L. Behavior of Escherichia coli O157:H7 in leafy vegetables. J. Food Prot. 2007, 70, 1966–1974. [Google Scholar] [CrossRef] [PubMed]
- Poirel, L.; Madec, J.-Y.; Lupo, A.; Schink, A.-K.; Kieffer, N.; Nordmann, P.; Schwarz, S. Antimicrobial resistance in Escherichia coli. Microbiol. Spectr. 2018, 6. [Google Scholar] [CrossRef] [PubMed]
- Gontijo, M.T.P.; Silva, J.d.S.; Vidigal, P.M.P.; Martin, J.G.P. Phylogenetic distribution of the bacteriocin repertoire of lactic acid bacteria species associated with artisanal cheese. Food. Res. Int. 2020, 128, 108783. [Google Scholar] [CrossRef]
- Lopez, M.E.S.; Gontijo, M.T.P.; Boggione, D.M.G.; Albino, L.A.A.; Batalha, L.S.; Mendonça, R.C.S. Microbiological Contamination in Foods and Beverages: Consequences and Alternatives in the Era of Microbial Resistance. In Microbial Contamination and Food Degradation; Holban, A.M., Grumezescu, A.M., Eds.; Academic Press: London, UK, 2018; pp. 49–84. [Google Scholar] [CrossRef]
- Gontijo, M.T.P.; Ramia, N.E.; Dijamentiuk, A.; Elfassy, A.; Taha, S.; Mangavel, C.; Revol-Junelles, A.-M.; Borges, F. Mining biosynthetic gene clusters in Carnobacterium maltaromaticum by interference competition network and genome analysis. Microorganisms 2022, 10, 1794. [Google Scholar] [CrossRef] [PubMed]
- Moye, Z.D.; Woolston, J.; Sulakvelidze, A. Bacteriophage applications for food production and processing. Viruses 2018, 10, 205. [Google Scholar] [CrossRef]
- Soffer, N.; Abuladze, T.; Woolston, J.; Li, M.; Hanna, L.F.; Heyse, S.; Charbonneau, D.; Sulakvelidze, A. Bacteriophages safely reduce Salmonella contamination in pet food and raw pet food ingredients. Bacteriophage 2016, 6, e1220347. [Google Scholar] [CrossRef]
- Abuladze, T.; Li, M.; Menetrez, M.Y.; Dean, T.; Senecal, A.; Sulakvelidze, A. Bacteriophages reduce experimental contamination of hard surfaces, tomato, spinach, broccoli, and ground beef by Escherichia coli O157: H7. Appl. Environ. Microbiol. 2008, 74, 6230–6238. [Google Scholar] [CrossRef]
- Jamal, M.; Bukhari, S.M.A.U.S.; Andleeb, S.; Ali, M.; Raza, S.; Nawaz, M.A.; Hussain, T.; Rahman, S.U.; Shah, S.S.A. Bacteriophages: An overview of the control strategies against multiple bacterial infections in different fields. J. Basic Microbiol. 2019, 59, 123–133. [Google Scholar] [CrossRef]
- Swanson, M.M.; Reavy, B.; Makarova, K.S.; Cock, P.J.; Hopkins, D.W.; Torrance, L.; Koonin, E.V.; Taliansky, M. Novel bacteriophages containing a genome of another bacteriophage within their genomes. PLoS ONE 2012, 7, e40683. [Google Scholar] [CrossRef] [PubMed]
- Krishnamurthy, S.R.; Janowski, A.B.; Zhao, G.; Barouch, D.; Wang, D. Hyperexpansion of RNA bacteriophage diversity. PLoS Biol. 2016, 14, e1002409. [Google Scholar] [CrossRef] [PubMed]
- Pham-Khanh, N.H.; Sunahara, H.; Yamadeya, H.; Sakai, M.; Nakayama, T.; Yamamoto, H.; Bich, V.T.T.; Miyanaga, K.; Kamei, K. Isolation, characterization and complete genome sequence of a Tequatrovirus phage, Escherichia phage KIT03, which simultaneously infects Escherichia coli O157:H7 and Salmonella enterica. Curr. Microbiol. 2019, 76, 1130–1137. [Google Scholar] [CrossRef] [PubMed]
- Fernández, L.; Gutiérrez, D.; García, P.; Rodríguez, A. The perfect bacteriophage for therapeutic applications—A quick guide. Antibiotics 2019, 8, 126. [Google Scholar] [CrossRef]
- Peng, Q.; Yuan, Y. Characterization of a newly isolated phage infecting pathogenic Escherichia coli and analysis of its mosaic structural genes. Sci. Rep. 2018, 8, 8086. [Google Scholar] [CrossRef] [PubMed]
- Tulio Pardini, G.M.; Silva, B.L.; Aguiar, A.L.A.; Elisa Soto, L.M. Bacteriophage genome sequencing: A new alternative to understand biochemical interactions between prokaryotic cells and phages. Microb. Biochem. Technol. 2017, 9, 4. [Google Scholar] [CrossRef]
- Galtier, M.; Sordi, L.D.; Maura, D.; Arachchi, H.; Volant, S.; Dillies, M.-A.; Debarbieux, L. Bacteriophages to reduce gut carriage of antibiotic resistant uropathogens with low impact on microbiota composition. Environ. Microbiol. 2016, 18, 2237–2245. [Google Scholar] [CrossRef]
- Sabouri Ghannad, M.; Mohammadi, A. Bacteriophage: Time to re-evaluate the potential of phage therapy as a promising agent to control multidrug-resistant bacteria. Iran. J. Basic Med. Sci. 2012, 15, 693–701. [Google Scholar] [CrossRef] [PubMed]
- Sillankorva, S.M.; Oliveira, H.; Azeredo, J. Bacteriophages and their role in food safety. Int. J. Microbiol. 2012, 2012, 863945. [Google Scholar] [CrossRef]
- García, R.; Latz, S.; Romero, J.; Higuera, G.; García, K.; Bastías, R. Bacteriophage production models: An overview. Front. Microbiol. 2019, 10, 1187. [Google Scholar] [CrossRef] [PubMed]
- Twort, F.W. An investigation on the nature of ultra-microscopic viruses. Lancet 1915, 186, 1241–1243. [Google Scholar] [CrossRef]
- D’Herelle, F. An invisible microbe that is antagonistic to the dysentery Bacillus. CR Acad. Sci. 1917, 165, 373–375. [Google Scholar]
- Zhao, F.; Shi, R.; Liu, R.; Tian, Y.; Yang, Z. Application of phage-display developed antibody and antigen substitutes in immunoassays for small molecule contaminants analysis: A mini-review. Food Chem. 2021, 339, 128084. [Google Scholar] [CrossRef]
- Hess, K.L.; Jewell, C.M. Phage display as a tool for vaccine and immunotherapy development. Bioeng. Transl. Med. 2020, 5, e10142. [Google Scholar] [CrossRef]
- Goracci, M.; Pignochino, Y.; Marchiò, S. Phage display-based nanotechnology applications in cancer immunotherapy. Molecules 2020, 25, 843. [Google Scholar] [CrossRef]
- Sioud, M. Phage display libraries: From binders to targeted drug delivery and human therapeutics. Mol Biotechnol. 2019, 61, 286–303. [Google Scholar] [CrossRef]
- Machera, S.J.; Niedziółka-Jönsson, J.; Szot-Karpińska, K. Phage-based sensors in medicine: A review. Chemosensors 2020, 8, 61. [Google Scholar] [CrossRef]
- Janczuk-Richter, M.; Marinović, I.; Niedziółka-Jönsson, J.; Szot-Karpińska, K. Recent applications of bacteriophage-based electrodes: A mini-review. Electrochem. Commun. 2019, 99, 11–15. [Google Scholar] [CrossRef]
- Wittebole, X.; De Roock, S.; Opal, S.M. A historical overview of bacteriophage therapy as an alternative to antibiotics for the treatment of bacterial pathogens. Virulence 2014, 5, 226–235. [Google Scholar] [CrossRef]
- Pirisi, A. Phage therapy—Advantages over antibiotics? Lancet 2000, 356, 1418. [Google Scholar] [CrossRef] [PubMed]
- Loc-Carrillo, C.; Abedon, S.T. Pros and cons of phage therapy. Bacteriophage 2011, 1, 111–114. [Google Scholar] [CrossRef] [PubMed]
- Örmälä, A.-M.; Jalasvuori, M. Phage therapy: Should bacterial resistance to phages be a concern, even in the long run? Bacteriophage 2013, 3, e24219. [Google Scholar] [CrossRef]
- Doss, J.; Culbertson, K.; Hahn, D.; Camacho, J.; Barekzi, N. A review of phage therapy against bacterial pathogens of aquatic and terrestrial organisms. Viruses 2017, 9, 50. [Google Scholar] [CrossRef]
- Cumby, N.; Reimer, K.; Mengin-Lecreulx, D.; Davidson, A.R.; Maxwell, K.L. The phage tail tape measure protein, an inner membrane protein and a periplasmic chaperone play connected roles in the genome injection process of E. coli phage HK 97. Mol. Microbiol. 2015, 96, 437–447. [Google Scholar] [CrossRef]
- Simmons, E.L.; Drescher, K.; Nadell, C.D.; Bucci, V. Phage mobility is a core determinant of phage–bacteria coexistence in biofilms. ISME. J. 2018, 12, 531–543. [Google Scholar] [CrossRef]
- Rostøl, J.T.; Marraffini, L. (Ph)ighting phages: How bacteria resist their parasites? Cell Host Microbe 2019, 25, 184–194. [Google Scholar] [CrossRef]
- Tock, M.R.; Dryden, D.T. The biology of restriction and anti-restriction. Curr. Opin. Microbiol. 2005, 8, 466–472. [Google Scholar] [CrossRef]
- Penadés, J.R.; Christie, G.E. The phage-inducible chromosomal islands: A family of highly evolved molecular parasites. Annu. Rev. Virol. 2015, 2, 181–201. [Google Scholar] [CrossRef]
- Hille, F.; Richter, H.; Wong, S.P.; Bratovič, M.; Ressel, S.; Charpentier, E. The biology of CRISPR-Cas: Backward and forward. Cell 2018, 172, 1239–1259. [Google Scholar] [CrossRef]
- Durmaz, E.; Klaenhammer, T.R. Abortive phage resistance mechanism AbiZ speeds the lysis clock to cause premature lysis of phage infected Lactococcus lactis. J. Bacteriol. 2007, 189, 1417–1425. [Google Scholar] [CrossRef]
- Harms, A.; Brodersen, D.E.; Mitarai, N.; Gerdes, K. Toxins, targets, and triggers: An overview of toxin-antitoxin biology. Mol. Cell 2018, 70, 768–784. [Google Scholar] [CrossRef]
- Hegge, J.W.; Swarts, D.C.; van der Oost, J. Prokaryotic argonaute proteins: Novel genome-editing tools? Nat. Rev. Microbiol. 2018, 16, 5–11. [Google Scholar] [CrossRef]
- Górski, A.; Międzybrodzki, R.; Węgrzyn, G.; Jończyk-Matysiak, E.; Borysowski, J.; Weber-Dąbrowska, B. Phage therapy: Current status and perspectives. Med. Res. Rev. 2020, 40, 459–463. [Google Scholar] [CrossRef]
- Keen, E.C.; Adhya, S.L. Phage therapy: Current research and applications. Clin. Infect. Dis. 2015, 61, 141–142. [Google Scholar] [CrossRef]
- Sultan-Alolama, M.I.; El-Tarabily, K.A.; Vijayan, R. Complete genome sequence of Escherichia coli O157: H7 phage UAE_MI-01, isolated from bird feces. Microbiol. Resour. Announc. 2021, 10, e00348-21. [Google Scholar] [CrossRef]
- Sultan-Alolama, M.I.; Amin, A.; El-Tarabily, K.A.; Vijayan, R. Characterization and genomic analysis of Escherichia coli O157:H7 phage UAE_MI-01 isolated from birds. Int. J. Mol. Sci. 2022, 23, 14846. [Google Scholar] [CrossRef]
- Villarroel, J.; Kleinheinz, K.A.; Jurtz, V.I.; Zschach, H.; Lund, O.; Nielsen, M.; Larsen, M.V. HostPhinder: A phage host prediction tool. Viruses 2016, 8, 116. [Google Scholar] [CrossRef]
- Page, A.J.; Seemann, T. TipToft: Detecting plasmids contained in uncorrected long read sequencing data. J. Open Source Softw. 2019, 4, 1021. [Google Scholar] [CrossRef]
- Yoichi, M.; Abe, M.; Miyanaga, K.; Unno, H.; Tanji, Y. Alteration of tail fiber protein Gp38 enables T2 phage to infect Escherichia coli O157:H7. J. Biotechnol. 2005, 115, 101–107. [Google Scholar] [CrossRef] [PubMed]
- Jun, J.W.; Giri, S.S.; Kim, H.J.; Yun, S.K.; Chi, C.; Chai, J.Y.; Lee, B.C.; Park, S.C. Bacteriophage application to control the contaminated water with Shigella. Sci. Rep. 2016, 6, 22636. [Google Scholar] [CrossRef]
- Mallick, B.; Mondal, P.; Dutta, M. Morphological, biological, and genomic characterization of a newly isolated lytic phage Sfk20 infecting Shigella flexneri, Shigella sonnei, and Shigella dysenteriae1. Sci. Rep. 2021, 11, 19313. [Google Scholar] [CrossRef] [PubMed]
- Lee, H.; Ku, H.-J.; Lee, D.-H.; Kim, Y.-T.; Shin, H.; Ryu, S.; Lee, J.-H. Characterization and genomic study of the novel bacteriophage HY01 infecting both Escherichia coli O157:H7 and Shigella flexneri: Potential as a biocontrol agent in food. PLoS ONE 2016, 11, e0168985. [Google Scholar] [CrossRef] [PubMed]
- Abedon, S.T. Bacteriophage T4 resistance to lysis-inhibition collapse. Genet. Res. 1999, 74, 1–11. [Google Scholar] [CrossRef]
- Bull, J.J.; Pfennig, D.W.; Wang, I.-N. Genetic details, optimization and phage life histories. Trends Ecol. Evol. 2004, 19, 76–82. [Google Scholar] [CrossRef]
- Paddison, P.; Abedon, S.T.; Dressman, H.K.; Gailbreath, K.; Tracy, J.; Mosser, E.; Neitzel, J.; Guttman, B.; Kutter, E. The roles of the bacteriophage T4 r genes in lysis inhibition and fine-structure genetics: A new perspective. Genetics 1998, 148, 1539–1550. [Google Scholar] [CrossRef]
- van den Berg, D.F.; van der Steen, B.A.; Costa, A.R.; Brouns, S.J. Phage TRNAs evade TRNA-targeting host defenses through anticodon loop mutations. Res. Sq. 2022. [Google Scholar] [CrossRef]
- Davis, J.E.; Sinsheimer, R.L. The replication of bacteriophage MS2: 1. transfer of parental nucleic acid to progeny phage. J. Mol. Biol. 1963, 6, 203–207. [Google Scholar] [CrossRef]
- Sambrook, J.; Fritsch, E.F.; Maniatis, T. Chapter 2: Bacteriophage λ vectors. In Molecular Cloning: A Laboratory Manual, 2nd ed.; Cold Spring Harbor Laboratory Press: New York, NY, USA, 1989; p. 1546. [Google Scholar]
- Vidaver, A.K.; Koski, R.K.; Van Etten, J.L. Bacteriophage Φ6: A lipid-containing virus of Pseudomonas phaseolicola. J. Virol. 1973, 11, 799–805. [Google Scholar] [CrossRef]
- Green, M.R.; Hughes, H.; Sambrook, J.; MacCallum, P. Chapter 1: Isolation and qualification of DNA. In Molecular Cloning: A Laboratory Manual; Cold Spring Harbor Laboratory Press: New York, NY, USA, 2012; p. 2028. [Google Scholar]
- Miles, A.A.; Misra, S.S.; Irwin, J.O. The estimation of the bactericidal power of the blood. J. Hyg. 1938, 38, 732–749. [Google Scholar] [CrossRef]
- Li, S.; Liu, L.; Zhu, J.; Zou, L.; Li, M.; Cong, Y.; Rao, X.; Hu, X.; Zhou, Y.; Chen, Z.; et al. Characterization and genome sequencing of a novel coliphage isolated from engineered Escherichia coli. Intervirology 2010, 53, 211–220. [Google Scholar] [CrossRef] [PubMed]
- Viazis, S.; Akhtar, M.; Feirtag, J.; Brabban, A.D.; Diez-Gonzalez, F. Isolation and characterization of lytic bacteriophages against enterohaemorrhagic Escherichia coli. J. Appl. Microbiol. 2011, 110, 1323–1331. [Google Scholar] [CrossRef]
- Khan Mirzaei, M.; Nilsson, A.S. Isolation of phages for phage therapy: A comparison of spot tests and efficiency of plating analyses for determination of host range and efficacy. PLoS ONE 2015, 10, e0118557. [Google Scholar] [CrossRef]
- Brownell, G.H.; Adams, J.N.; Bradley, S.G. Growth and characterization of nocardiophages for Nocardia canicruria and Nocardia erythropolis Mating Types. J. Gen. Microbiol. 1967, 47, 247–256. [Google Scholar] [CrossRef]
- Dowding, J.E. Characterization of a bacteriophage virulent for Streptomyces coelicolor A3 (2). J. Gen. Microbiol. 1973, 76, 163–176. [Google Scholar] [CrossRef]
- Sykes, I.K.; Lanning, S.; Williams, S.T. The effect of pH on soil actinophage. Microbiology 1981, 122, 271–280. [Google Scholar] [CrossRef]
- Ackermann, H.-W.; Heldal, M. Basic electron microscopy of aquatic viruses. In Manual of Aquatic Viral Ecology; The Association for the Sciences of Limnology and Oceanography: Waco, TX, USA, 2010; Chapter 18; pp. 182–192. [Google Scholar] [CrossRef]
- Brum, J.R.; Steward, G.F. Morphological characterization of viruses in the stratified water column of alkaline, hypersaline mono lake. Microb. Ecol. 2010, 60, 636–643. [Google Scholar] [CrossRef]
- Russell, D.A. Sequencing, assembling, and finishing complete bacteriophage genomes. Methods Mol. Biol. 2018, 1681, 109–125. [Google Scholar] [CrossRef]
- Darling, A.E.; Mau, B.; Perna, N.T. progressiveMauve: Multiple genome alignment with gene gain, loss and rearrangement. PLoS ONE 2010, 5, e11147. [Google Scholar] [CrossRef] [PubMed]
- Tamura, K.; Stecher, G.; Kumar, S. MEGA11: Molecular evolutionary genetics analysis version 11. Mol. Biol. Evol. 2021, 38, 3022–3027. [Google Scholar] [CrossRef] [PubMed]

| Bacterial Strains | Sensitivity to Phage Ec_MI-02 |
|---|---|
| Escherichia coli O157:H7 NCTC 12900 | ++ |
| Escherichia coli O157:H7 (Patient isolate 1) | ++ |
| Escherichia coli O157:H7 (Patient isolate 2) | ++ |
| Escherichia coli O157:H7 (Patient isolate 3) | ++ |
| Escherichia coli O157:H7 (Green salad) | ++ |
| Escherichia coli O157:H7 (Ground beef) | ++ |
| Escherichia coli ATCC 8739 | ++ |
| Escherichia coli ATCC 25922 | − |
| Escherichia coli ATCC 35218 | + |
| Escherichia coli ATCC NCTC 13841 | + |
| Escherichia coli ATCC 15223 | + |
| Escherichia coli ATCC 23227 | + |
| Escherichia coli ATCC 9637 | + |
| Escherichia coli ATCC 23224 | + |
| Escherichia coli (Patient isolate—urine) | + |
| Escherichia coli ESBL-producing (Patient isolate—blood) | − |
| Bacillus subtilis ATCC 6051 | − |
| Pseudomonas aeruginosa ATCC 25668 | − |
| Pseudomonas aeruginosa ATCC 27853 | − |
| Methicillin-resistant Staphylococcus aureus (Patient isolate) | − |
| Staphylococcus aureus ATCC 6358 | − |
| Staphylococcus aureus ATCC 29213 | − |
| Staphylococcus epidermidis ATCC 12228 | − |
| Staphylococcus saprophyticus ATCC-BAA 750 | − |
| Streptococcus pyogenes ATCC 19615 | − |
| Enterococcus faecalis ATCC 51299 | − |
| Enterococcus faecalis (Patient isolate) | − |
| Enterococcus casseliflavus (Patient isolate) | − |
| Enterobacter aerogenes ATCC 13018 | − |
| Enterobacter hormaechei (Patient isolate) | − |
| Klebsiella pneumonia ESBL-producing ATCC 700603 | − |
| Klebsiella pneumonia KPC 2 +ve (Patient isolate) | − |
| Haemophilus influenzae ATCC 9007 | − |
| Stenotrophomonas maltophilia ATCC 17666 | − |
| Salmonella enterica ATCC 14028 | − |
| Salmonella sp. (Patient isolate) | − |
| Proteus vulgaris ATCC 29905 | − |
| Mycobacterium smegmatis ATCC 607 | − |
| Bacterial Strains | EOP |
|---|---|
| Escherichia coli O157:H7 (patient isolate 1) | High production (0.86) |
| Escherichia coli O157:H7 (patient isolate 2) | High production (0.9) |
| Escherichia coli O157:H7 (patient isolate 3) | High production (0.89) |
| Escherichia coli O157:H7 (green salad) | High production (0.89) |
| Escherichia coli O157:H7 (ground beef) | High production (0.9) |
| Escherichia coli ATCC 8739 | High production (0.6) |
| Escherichia coli ATCC 35218 | No production (no plaques) |
| Escherichia coli ATCC NCTC 13841 | Low production (0.006) |
| Escherichia coli ATCC 15223 | Low production (0.03) |
| Escherichia coli ATCC 23227 | Low production (0.03) |
| Escherichia coli ATCC 9637 | Low production (0.03) |
| Escherichia coli ATCC 23224 | No Production (no plaques) |
| Escherichia coli (Patient isolate—urine) | No production (0.00002) |
| pH | Initial Titer (IT) | 3 | 4 | 7 | 9 | 10 |
|---|---|---|---|---|---|---|
| log10 pfu/mL | 5.85 ± 0.12 a | 5.93 ± 0.048 a | 5.96 ± 0.047 a | 5.91 ± 0.10 a | 5.89 ± 0.10 a | 5.92 ± 0.13 a |
| (log10 pfu/mL) | |||||||||
|---|---|---|---|---|---|---|---|---|---|
| Temperature/Time | Initial Titer (IT) | −20 °C | 4 °C | 25 °C | 45 °C | 55 °C | 65 °C | 75 °C | 100 °C |
| 15 min | 5.76 ± 0.082 Aa | 5.71 ± 0.023 Aa | 5.73 ± 0.054 Aa | 5.75 ± 0.078 Aa | 5.46 ± 0.055 Ab | 5.23 ± 0.087 Ac | 4.91 ± 0.080 Ad | 0.00 ± 0.00 Ae | 0.00 ± 0.00 Ae |
| 30 min | 5.55 ± 0.078 Aa | 5.57 ± 0.043 Aa | 5.59 ± 0.056 Aa | 5.61 ± 0.055 Aa | 5.43 ± 0.032 Ab | 5.19 ± 0.114 Ac | 4.85 ± 0.067 Ad | 0.00 ± 0.00 Ae | 0.00 ± 0.00 Ae |
| Disinfectant | Initial Titer (IT) (log10 pfu/mL) | After 30 s (log10 pfu/mL) | After 60 s (log10 pfu/mL) | After 120 s (log10 pfu/mL) |
|---|---|---|---|---|
| Ethanol 70% | 6.19 ± 0.028 Aa | 6.16 ± 0.060 Aa | 5.96 ± 0.134 Ab | 5.91 ± 0.155 Ab |
| Commercial disinfectant 20% | 6.20 ± 0.057 Aa | 5.44 ± 0.121 Bb | 4.75 ± 0.149 Bc | 3.14 ± 0.240 Bd |
| Sodium hypochlorite 2% | 6.18 ± 0.075 Aa | 0.00 ± 0.00 Cb | 0.00% ± 0.00 Cb | 0.00% ± 0.00 Cb |
| Bacteriophage | E-Value | Query Coverage | Percentage Identity | Genome Size (bp) | NCBI Accession |
|---|---|---|---|---|---|
| Shigella phage pSs-1 | 0.0 | 97% | 98.56% | 164,999 | NC_025829.1 |
| Shigella phage Sfk20 | 0.0 | 96% | 98.44% | 164,878 | MW341595.1 |
| Shigella phage KNP5 | 0.0 | 97% | 98.27% | 193,624 | NC_055713.1 |
| Escherichia phage PEC04 | 0.0 | 96% | 97.57% | 167,552 | KR233165.1 |
| Escherichia phage HY01 | 0.0 | 96% | 97.57% | 166,977 | KF925357.1 |
| Escherichia phage HY03 | 0.0 | 91% | 97.38% | 170,770 | KR269718.1 |
| Escherichia phage vB_EcoM_IME537 | 0.0 | 95% | 97.18% | 168,642 | NC_054921.1 |
| Escherichia phage vB_vPM_PD112 | 0.0 | 93% | 97.07% | 168,084 | NC_054928.1 |
| Escherichia phage vB_Eco_NR1 | 0.0 | 92% | 96.95% | 167,153 | LR990704.1 |
| Escherichia phage vB_EcoM_CE1 | 0.0 | 94% | 96.93% | 167,955 | ON229909.1 |
Disclaimer/Publisher’s Note: The statements, opinions and data contained in all publications are solely those of the individual author(s) and contributor(s) and not of MDPI and/or the editor(s). MDPI and/or the editor(s) disclaim responsibility for any injury to people or property resulting from any ideas, methods, instructions or products referred to in the content. |
© 2023 by the authors. Licensee MDPI, Basel, Switzerland. This article is an open access article distributed under the terms and conditions of the Creative Commons Attribution (CC BY) license (https://creativecommons.org/licenses/by/4.0/).
Share and Cite
Sultan-Alolama, M.I.; Amin, A.; Vijayan, R.; El-Tarabily, K.A. Isolation, Characterization, and Comparative Genomic Analysis of Bacteriophage Ec_MI-02 from Pigeon Feces Infecting Escherichia coli O157:H7. Int. J. Mol. Sci. 2023, 24, 9506. https://doi.org/10.3390/ijms24119506
Sultan-Alolama MI, Amin A, Vijayan R, El-Tarabily KA. Isolation, Characterization, and Comparative Genomic Analysis of Bacteriophage Ec_MI-02 from Pigeon Feces Infecting Escherichia coli O157:H7. International Journal of Molecular Sciences. 2023; 24(11):9506. https://doi.org/10.3390/ijms24119506
Chicago/Turabian StyleSultan-Alolama, Mohamad Ismail, Amr Amin, Ranjit Vijayan, and Khaled A. El-Tarabily. 2023. "Isolation, Characterization, and Comparative Genomic Analysis of Bacteriophage Ec_MI-02 from Pigeon Feces Infecting Escherichia coli O157:H7" International Journal of Molecular Sciences 24, no. 11: 9506. https://doi.org/10.3390/ijms24119506
APA StyleSultan-Alolama, M. I., Amin, A., Vijayan, R., & El-Tarabily, K. A. (2023). Isolation, Characterization, and Comparative Genomic Analysis of Bacteriophage Ec_MI-02 from Pigeon Feces Infecting Escherichia coli O157:H7. International Journal of Molecular Sciences, 24(11), 9506. https://doi.org/10.3390/ijms24119506

